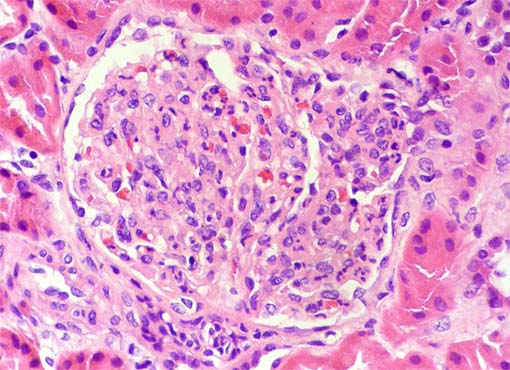

CASO
39 (Mayo de 2009)
Datos clínicos
Niña de 13 años de edad,
con antecedente de síndrome nefrótico desde los dos años
de edad, con recaídas múltiples, aproximadamente 1 a 2 por
año, que responden al tratamiento con esteroides. No otros antecedentes
patológicos.
Evaluada en Nefrología por cuadro
de malestar general, edemas y hematuria macro, aproximadamente una semana
de evolución. Nunca antes las recaídas de su síndrome
nefrótico se habían presentado así.
La paciente había sido evaluada
por dermatólogo una semana antes del inicio del cuadro por lesiones
en piel de varias semanas de evolución; su impresión diagnóstica
fue de prúrigo nodular.
Al exámen físico: presión
arterial 130/80, pulso 88/min, FR: 16/min. Edemas en cara y miembros inferiores.
Lesiones papulo-nodulares en piel, algunas eritematosas. No otras alteraciones.
Paraclínicos:
Hemoleucograma con valores en rangos normales. Proteinuria: 53 mg/m2/h,
leucocitos: 18 por campo de gran aumento (CGA); eritrocitos 50 CGA; cilíndros
granulosos y hemáticos. Creatinina sérica: 1,2 mg/dL; BUN
29 mg/dL.
ANAs negativos; anti-DNA negativo. C3:
58 (90-180); C4 23,3 (10-40)
¿Cuál es su diagnóstico
clínico?
Observe las imágenes
de la biopsia renal.

Figura 1.
Algunos pequeños focos de inflamación tubulointersticial.
H&E, X100.

Figura 2.
H&E, X200.

Figura 3.
H&E, X400.
Figura 4.
H&E, X400.

Figura 5.
H&E, X400.

Figura 6.
Tricrómico de Masson, X400.

Figura 7.
Plata-metenamina, X400.

Figura 8.
Inmunofluorescencia directa para IgG, X400.

Figura 9.
Inmunofluorescencia directa para C3, X400.

Figura 10.
Inmunofluorescencia directa para C1q, X400.
Inmunofluorescencia directa para IgA
e IgM: Negativas.
¿Cuál es su diagnóstico?
Ver
diagnóstico y discusión
[Arriba]
|